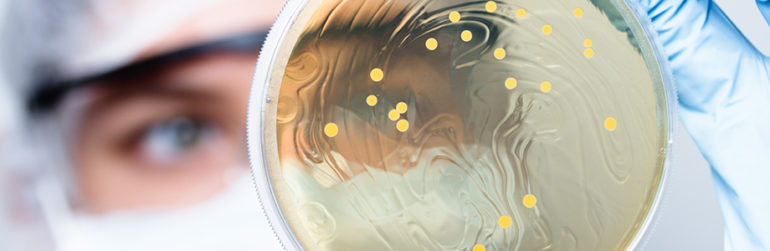
microbiote-obesite-signature-plasma

Selon une étude suédoise, l’altération du microbiote observée dans l’obésité est associée à la présence de certains métabolites dans le plasma. Une sorte de signature sanguine du microbiote intestinal.
Plusieurs études ont déjà montré que le microbiote intestinal affectait le métabolisme. Ces désordres métaboliques sont avancés comme une piste susceptible d’accroître le risque de pathologies telles que l’obésité, le diabète de type II et les maladies cardiovasculaires.
Les chercheurs s’intéressent donc de plus en plus aux métabolites présents dans le plasma et à leur relation éventuelle avec une situation métabolique perturbée, ce que l’on appelle la métabolomie.
Microbiote et métabolites sanguins
Des chercheurs de l’Université de Lund ont analysé des échantillons de sang et de selles de 674 personnes. Ils ont dosé pas moins de 48 métabolites plasmatiques, le but étant d’identifier quels métabolites seraient associés à l’obésité.
Il ressort que 19 métabolites différents s’avèrent associés à un BMI élevé, donc à un risque accru d’obésité. Les principaux métabolites incriminés sont la glutamine et les acides aminés branchés et aromatiques (BCAA).
Quatre genres bactériens associés aux métabolites
Autre constat majeur de cette recherche, c’est que les métabolites associés au BMI sont aussi liés à 4 genres de bactéries intestinales différents (L. Blautia, L. Dorea et L. Ruminococcus et SHA-98). Autrement dit, cette étude montre qu’il existe des interactions entre le microbiote intestinal, le profil métabolique sanguin et le risque d’obésité.
La prochaine mission sera de trouver une façon de modifier la flore intestinale, avec pour objectif de normaliser les métabolites plasmatiques, et l’espoir de réduire le risque d’obésité et de maladies corrélées. Enfin, le microbiote et ses effets sont différents chez chacun. Il serait donc intéressant de mettre en place une étude plus large, avec un échantillon plus important.